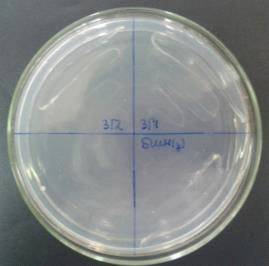
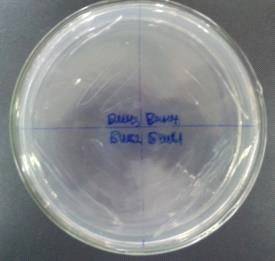

Материал: Изучение влияния температуры на нефтеокисляющую активность микроорганизмов-кандидатов в ассоциацию-деструктор
Идентификацию культур проводили общепринятыми методами на основании изучения морфологических, культуральных и физиолого-биохимических признаков. Форму, величину, подвижность, наличие или отсутствие спор, окрашивание по Грамму изучали с помощью лабораторного микроскопа «Mоtiс BА 300» по общепринятым в лабораторной практике методикам. Морфологию и структуру колоний определяли при росте на МПА. Для идентификации бактерий использовали определитель Берги [44].
Результаты изучения морфолого-культуральных и физиологических признаков бактерий БШС-1, БШС-2, БШН-1, БШН-2, БШН-3, БШН-4, ЗГ-1, ЗГ-2, БШН (ц) и БВН-1 представлены в таблицах 3, 4, 5.
Таблица 3.
Макро- и микроморфологическая характеристика культур аборигенных культур микроорганизмов
|
№ |
Культура |
Описание колоний |
Морфология клеток, х1300 |
Размеры клеток, мкм |
|
1. |
БШС-1 |
круглые с ровными краями, плоские, гладкие, желто-оранжевые, непрозрачные, блестящие колонии, диаметр 1-3мм |
Мелкие палочки, расположены поодиночке |
0,5-1,5 |
|
2. |
БШС-2 |
круглые с ровными краями, плоские, молочные, полупрозрачные, блестящие, диаметр 1-3 мм |
Мелкие палочки, расположены поодиночке |
0,7-1,6 |
|
3. |
БШН-1 |
круглые с ровными краями, плоские, морщнистые, молочные, непрозрачные, матовые, диаметр 2-5мм |
Крупные палочки, расположены поодиночке |
1,2-3,6 |
|
4. |
БШН-2 |
круглые с ровными краями, плоские, морщнистые, молочные, непрозрачные, матовые, диаметр 1-3 мм |
Мелкие палочки, расположены поодиночке |
0,5-1,7 |
|
5. |
БШН-3 |
круглые с ровными краями, выпуклые, складчато-морщинистые, белые, полупрозрачные, блестящие, диаметр 2-6мм |
Крупные одиночные и соединенные попарно палочки |
1,6-4 |
|
6. |
БШН-4 |
круглые с ровными краями, плоские, гладкие, белые, полупрозрачные, блестящие, диаметр 2-5мм |
Крупные палочки, расположены поодиночке и попарно |
1,5-3,5 |
|
7. |
ЗГ-1 |
круглые с ровными краями, выпуклые, гладкие, молочные, прозрачные, блестящие, диаметр 1-2 мм |
Мелкие палочки, расположены поодиночке |
0,6-1,6 |
|
8. |
ЗГ-2 |
круглые с ровными краями, выпуклые, гладкие, желтые, прозрачные, блестящие, диаметр 1-2 мм |
Мелкие палочки, расположены поодиночке |
0,6-1,8 |
|
9. |
БШЦ-(ц) |
круглые с ровными краями, выпуклые, шероховатые, молочные, непрозрачные, блестящие, диаметр 1-2 мм |
Мелкие палочки, расположены поодиночке |
0,5-1,5 |
|
10. |
БВН-1 |
круглые с ровными краями, плоские, шероховатые, молочные, прозрачные, блестящие, диаметр 1-2 мм |
Мелкие палочки, расположены поодиночке |
0,6-1,6 |
В таблице 3 дано описание морфологий колоний и клеток, а также размеров клеток, выделенных нами культур.
Согласно результатам, представленным в таблице
4, видно что, клетки всех культур являются денитрифицирующими подвижными
палочками, обладающими каталазной активностью, а клетки культур БШН-1, БШН-3,
БШН-4 относятся к спорообразующим, грамотрицательным моно- и диплобактериям.
Таблица 4.
Основные дифференциально-диагностические признаки выделенных бактерий
|
№ п/п |
Культура |
Окраска по Граму |
Подвижность |
Споры |
Гидролиз желатины |
Наличие каталазы |
Наличие оксидазы |
Денитрификация |
|
1 |
БШС-1 |
- |
+ |
- |
- |
+ |
+ |
+ |
|
2 |
БШС-2 |
- |
+ |
- |
+ |
+ |
+ |
+ |
|
3 |
БШН-1 |
+ |
+ |
+ |
+ |
+ |
+ |
+ |
|
4 |
БШН-2 |
- |
+ |
- |
+ |
+ |
+ |
+ |
|
5 |
БШН-3 |
+ |
+ |
+ |
+ |
+ |
+ |
+ |
|
6 |
БШН-4 |
+ |
+ |
+ |
+ |
+ |
+ |
+ |
|
7 |
ЗГ-1 |
+ |
- |
+ |
+ |
+ |
+ |
|
|
8 |
ЗГ-2 |
- |
+ |
- |
+ |
+ |
- |
+ |
|
9 |
БШН-(ц) |
- |
+ |
- |
- |
+ |
+ |
+ |
|
10 |
БВН1 |
- |
+ |
- |
+ |
+ |
+ |
+ |
Усвоение углеводов определяли по потреблению
углеводов в течение 2-х недель на средах, содержавших соответствующие растворы
сахаров (в концентрации 1%) с добавлением индикатора бромтимолблау (0,016 %
спиртовой раствор). Полученные данные представлены в таблице 5. Как видно, все
культуры сбраживают углеводы и спирты, следует отметить, что все культуры кроме
ЗГ-2, которая при сбраживании маннита образует щелочь и газ, сбраживают
исследуемые источники углерода до кислоты и газа, тогда как при ферментации
глицерина все культуры образуют только кислоты.
Таблица 5.
Усвоение углеводов культурами выделенных бактерий
|
Углеводы |
Культуры |
|||||||||||
|
|
БШС-1 |
БШС-2 |
БШН-1 |
БШН-2 |
БШН-3 |
БШН-4 |
ЗГ-1 |
ЗГ-2 |
БШН-ц |
БШН |
БВН-1 |
|
|
1 |
2 |
3 |
4 |
5 |
6 |
7 |
8 |
9 |
10 |
11 |
12 |
|
|
Углеводы |
||||||||||||
|
Глюкоза |
к, г |
к |
к, г |
к, г |
к, г |
к, г |
к, г |
к |
к, г |
к |
к, г |
|
|
Ксилоза |
к, г |
к, г |
к, г |
к, г |
к |
к, г |
к, г |
к |
к, г |
к, г |
к, г |
|
|
Сахароза |
к, г |
к |
к, г |
к, г |
к, г |
к |
к, г |
к |
к, г |
к, г |
к |
|
|
Галактоза |
к |
к, г |
к |
к, г |
к, г |
к, г |
к, г |
к |
к, г |
к, г |
к,г |
|
|
Мальтоза |
к, г |
к, г |
к, г |
к |
к, г |
к, г |
к, г |
к, г |
к, г |
К |
к,г |
|
|
Лактоза |
к |
к, г |
к, г |
к, г |
к |
к |
к, г |
к, г |
к, г |
К |
к, г |
|
|
Арабиноза |
к |
к |
к, г |
к, г |
к, г |
к, г |
к, г |
к, г |
к, г |
к, г |
к |
|
|
Фруктоза |
к, г |
к, г |
к, г |
к, г |
к |
к |
к |
к, г |
к, г |
К |
к, г |
|
|
Спирты |
||||||||||||
|
глицерин |
к |
к |
к |
к |
к |
к |
к |
к |
к |
к |
к |
|
|
маннит |
к, г |
к, г |
к, г |
к, г |
к, г |
к, г |
к, г |
щ, г |
к, г |
к, г |
к,г |
|
|
Примечание - к - кислота, г - газ, щ - щелочь, б/и - без изменений |
||||||||||||
На рисунке 5 представлены микрофотографии клеток
культур БШН-3, БШН-1, БШН-4, БВН-1. Как видно, культура БШН-3 и БШН-4
представлена крупными одиночными и соединенными попарно палочками,
БШН-1 и БВН-1 - одиночные палочки.

БШН-3

БШН-1

БШН-4

БВН-1
Рисунок 5. Морфология клеток культур, выделенных
из буровых сточных вод и шлама, х1000
На основании результатов
морфолого-культуральных и физиолого-биохимических признаков, выделенные культуры
бактерий
идентифицированы нами как представители родов Рsеudоmоnаs
и Bасillus,
а именно: культуры БШС-1, БШС-2, БШН-2, ЗГ-1,
ЗГ-2, БШН -(ц), БВН-1
отнесены к роду Рsеudоmоnаs,
культуры БШН-1, БШН-3, БШН-4 отнесены к роду Bасillus.
3.2 Изучение
нефтеокисляющей активности микроорганизмов при различных температурных режимах
Эффективность применения биопрепаратов в разных почвенно-климатических зонах, для удаления определенных по химическому составу загрязнений обусловлена физиолого-биохимическими свойствами штаммов - биодеструкторов (термотолерантность, осмофильность, оптимальные для роста значения рН и др.). Одним из приоритетных решений для Западного Казахстана является использование биологических методов очистки от нефтезагрязнений с применением микроорганизмов-деструкторов способных функционировать при экстремальных температурах.
В наших исследованиях для изучения интенсивности роста 10 аборигенных культур микроорганизмов: Рs. ssр. БШС-1,Рs. ssр. БШС-2, Bас. ssр. БШН-1, Рs. ssр. БШН-2, Bас. ssр. БШН-3, Bас. ssр. БШН-4, Рs. ssр. ЗГ-1, Рs. ssр. ЗГ-2, Рs. ssр. БШН-(ц), Рs. ssр. БВН, а также коллекционной Рs. аеruginоsа Н14 проводили культивирование при температурах +5°С, +20°С +60°С на универсальной среде.
Результаты изучения интенсивности роста 10
углеводородокисляющих аборигенных культур микроорганизмов и Рs.
аеruginоsа
Н14 при различных температурах представлены в таблице 6. В качестве контроля
использовали вариант роста микроорганизмов при +37°С.
Таблица 6.
Рост микроорганизмов при различных температурах в течении 24 часов
|
№ |
Культуры микроорганизмов |
Интенсивность роста |
||
|
|
|
+37°С |
+5°С |
+20°С |
|
1. |
Рs. ssр. БШС-1 |
++ |
- |
++ |
|
2. |
Рs. ssр. БШС-2 |
++ |
- |
++ |
|
3. |
Bас. ssр. БШН-1 |
+++ |
- |
++ |
|
4. |
Рs. ssр. БШН-2 |
+++ |
- |
++ |
|
5. |
Bас. ssр. БШН-3 |
+++ |
- |
+++ |
|
6. |
Bас. ssр. БШН-4 |
+++ |
- |
++ |
|
7. |
Рs. ssр. ЗГ-1 |
++ |
+ |
++ |
|
8. |
Рs. ssр. ЗГ-2 |
+++ |
- |
+++ |
|
9. |
Рs. ssр. БШН-(ц) |
+++ |
+ |
++ |
|
10. |
Рs. ssр. БВН |
+++ |
+ |
++ |
|
11. |
Рs. аеrоgеnоsа Н14 |
+++ |
- |
++ |
|
Примечание:"-"- роста нет, "+"-слабый рост, "++"- умеренные рост, "+++"- обильный рост. |
||||
Как видно, при +5°С все культуры не способны к росту, кроме культур Рs. ssр. ЗГ-1, Рs. ssр. БШН-(ц), Рs. ssр. БВН для которых наблюдается слабый рост, тогда как при +20°С для 2 культур наблюдается обильный рост: Bас. ssр. БШН-3, Рs. ssр. ЗГ-2, а для остальных 9 культур - умеренный рост клеток. В контроле у всех культур наблюдается обильный рост, кроме 2 культур Рs. ssр. ЗГ-1 и Рs. ssр. БШС-2 которые показали умеренный рост.
На рисунке 6, 7 представлены фотографии роста
углеводородокисляющих культур при температуре +5°С и +20°С в течении 24 часов.

Культуры ЗГ-1, ЗГ-2, БШН-(ц) Культуры БШС-1, БШС-2, БШН-3, БШН-4
Рисунок 6. Рост углеводородокисляющих культур
микроорганизмов на МПА при +5°С


Культуры БШС-1, БШС-2, ЗГ-1, Зг-2 Культуры БШН-1, БШН-2, БШН-3, БШН-4
Рисунок 7. Оценка интенсивности роста
исследуемых культур микроорганизмов при температуре +20°С
Как видно на рисунке 6, рост культур Рsеudоmоnаs ssр. ЗГ-1 и Рsеudоmоnаs ssр. БШН-(ц) слабый, а для культур Рsеudоmоnаs ssр. БШС-1, Рsеudоmоnаs ssр. БШС-2, Bасillus ssр. БШН-3, Bасillus ssр. БШН-4 не наблюдается, а на рисунке 7 видно, что у культур Bасillus ssр. БШН-3, Рs. ssр. ЗГ-2 наблюдается обильный рост, у остальных культур Рs. ssр. БШС-1, Рs. ssр. БШС-2, Bас. ssр. БШН-1, Рs. ssр. БШН-2, Bас. ssр. БШН-4, Рs. ssр. ЗГ-1 наблюдался умеренный рост.
Резко-континентальный климат Западного Казахстана предполагает жаркое лето, с нагреванием поверхности почвы до +65°С, в связи с чем, было проведено изучение роста углеводородокисляющих культур при +60°С на жидкой среде МПБ.
В таблице 7 представлены результаты изменения
ОМЧ при культивировании при +60°С.
Таблица 7.
Изменение ОМЧ углеводородокисляющих культур микроорганизмов при культивировании при +60°С
|
№ |
Название культур |
Исходная среда с инокулятом, КОЕ/мл, 105 |
После 24-ч. культивирования КОЕ/мл,105 |
|
1 |
Рs. ssр. БШС-1 |
96 |
5,92 |
|
2 |
Рs. ssр. БШС-2 |
139 |
1,92 |
|
3 |
Bас. ssр. БШН-1 |
289 |
6,72 |
|
4 |
Рs. ssр. БШН-2 |
23,4 |
13,4 |
|
5 |
Bас. ssр. БШН-3 |
122 |
6,24 |
|
6 |
Bас. ssр. БШН-4 |
41,5 |
9,1 |
|
7 |
Рs. ssр. ЗГ-1 |
359 |
0,54 |
|
8 |
Рs. ssр. ЗГ-2 |
413 |
2,2 |
|
9 |
Рs. ssр. БШН-(ц) |
36,1 |
0,08 |
|
10 |
Рs. ssр. БВН |
151 |
10,6 |
|
11 |
Рs. аеruginоsа Н14 |
153 |
0,01 |